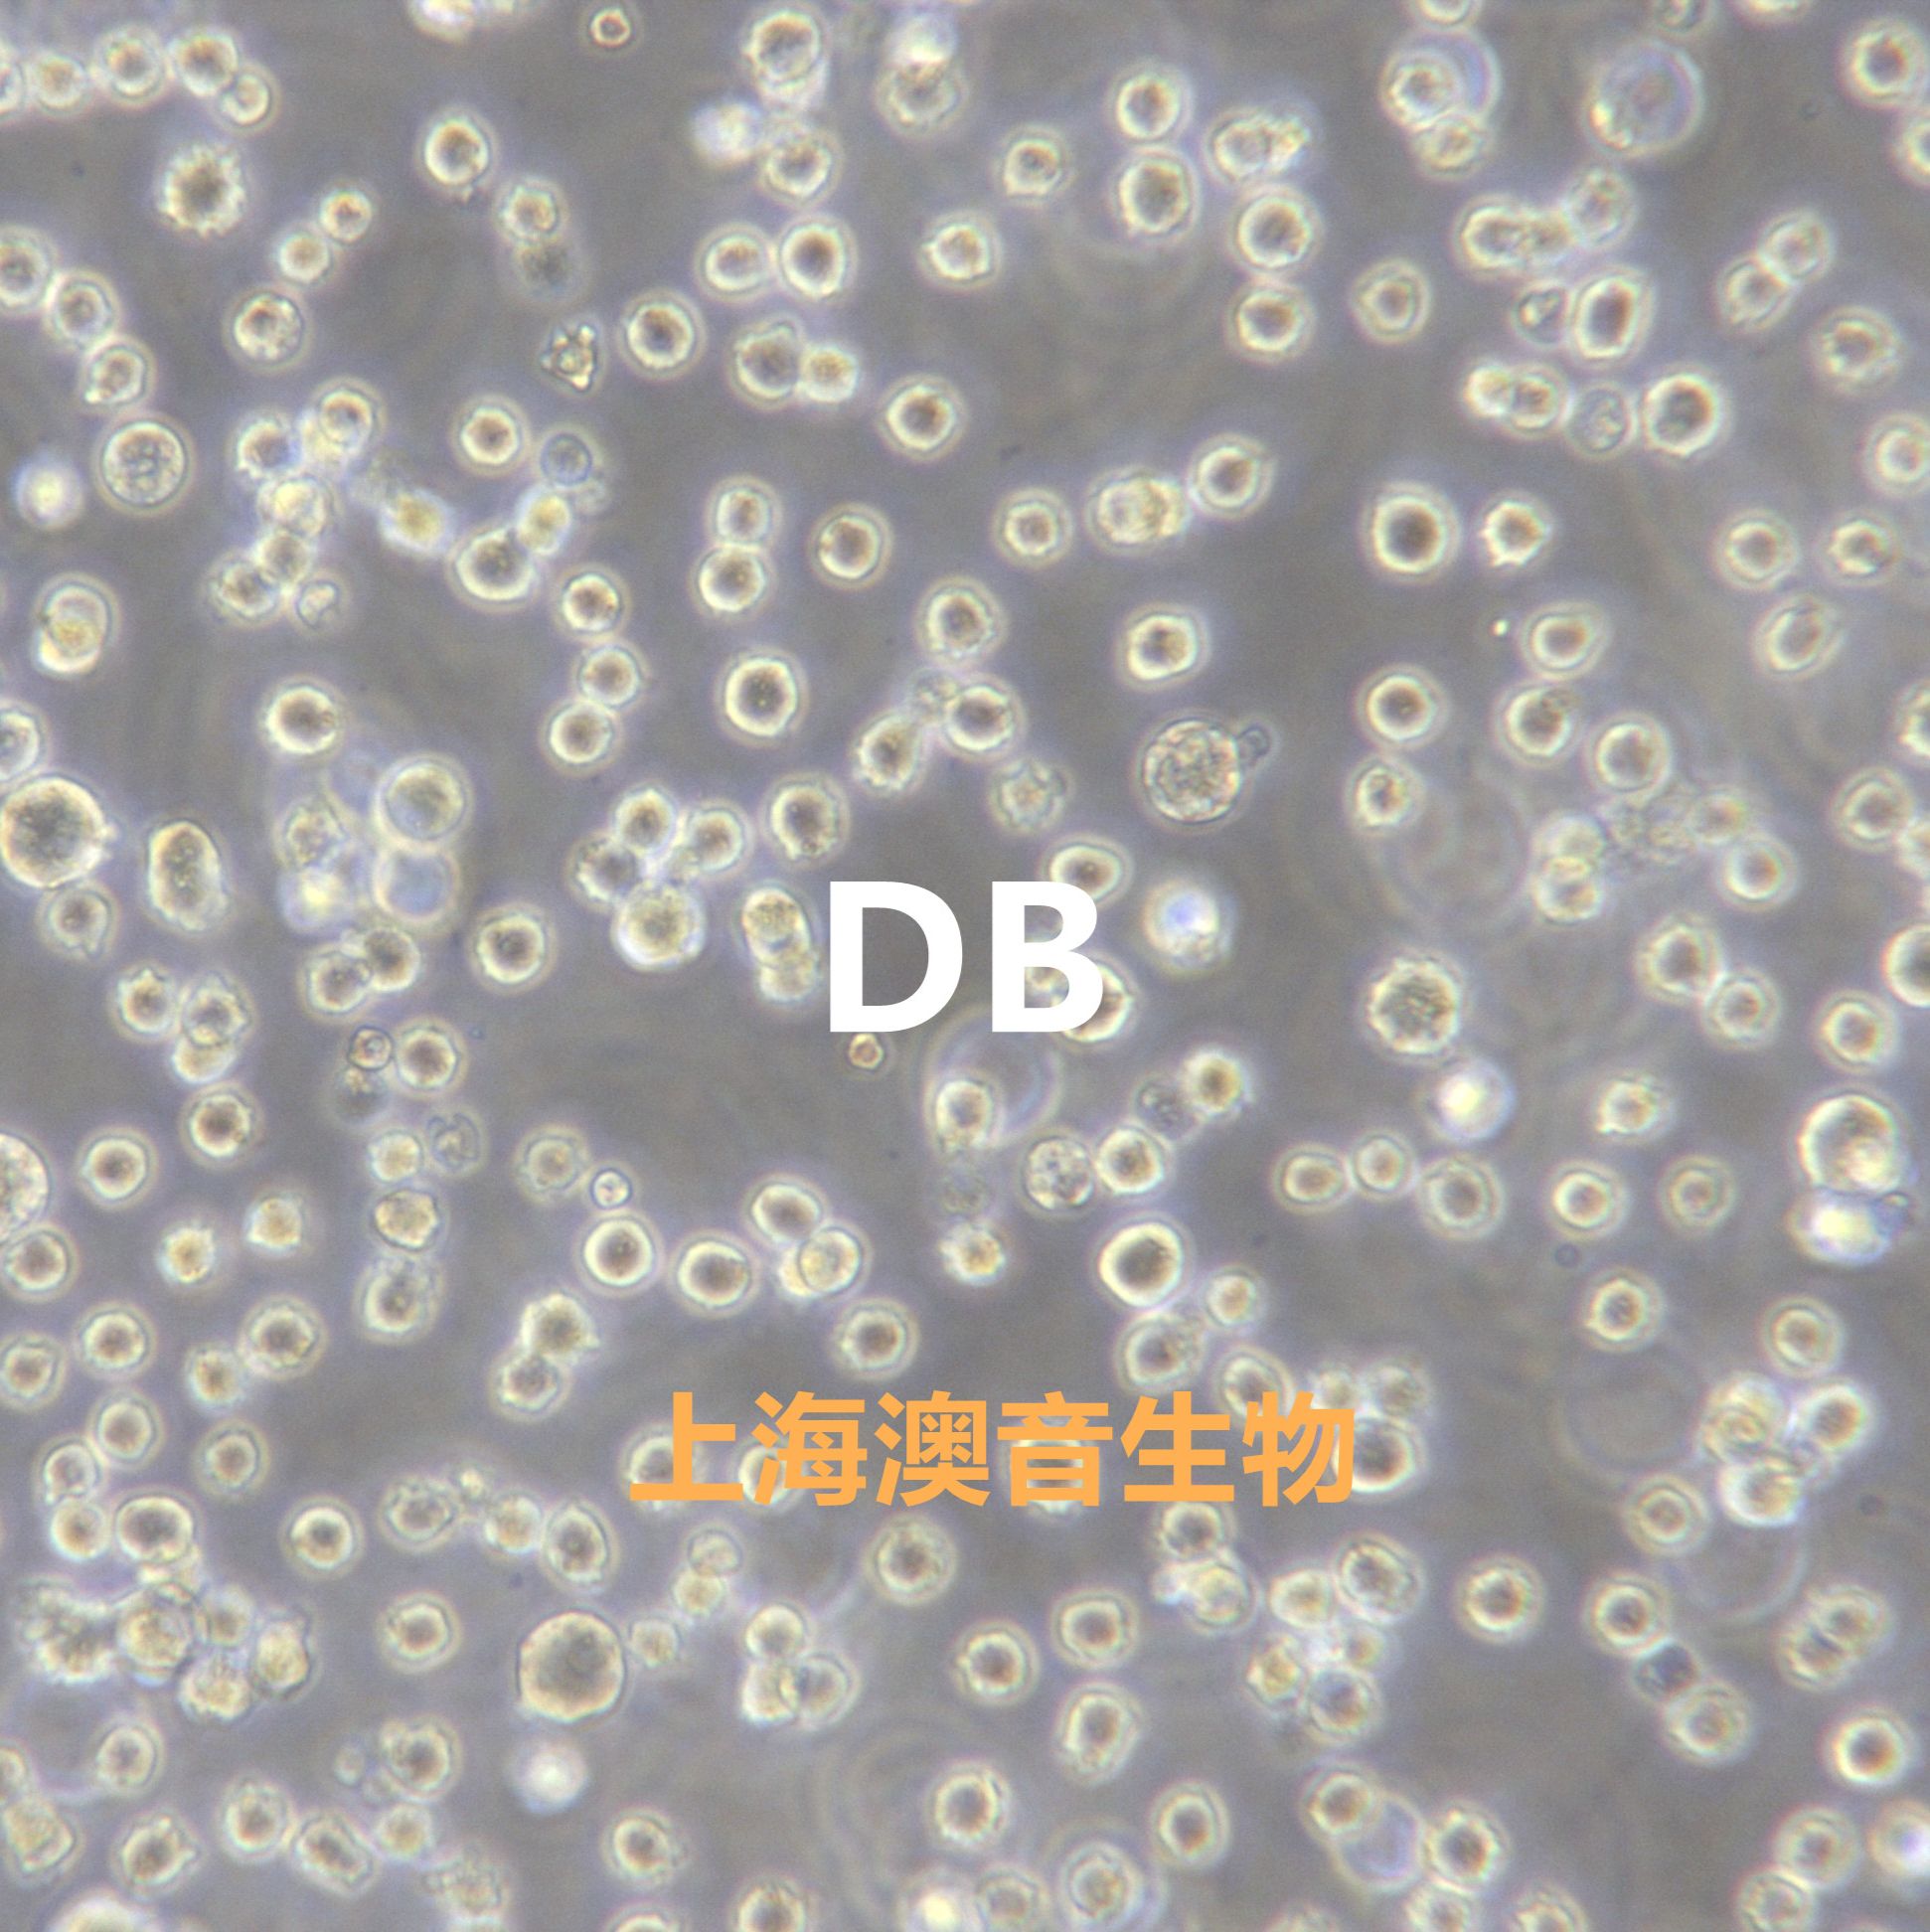
产品封面图

相关产品推荐更多 >
万千商家帮你免费找货
0 人在求购买到急需产品
- 详细信息
- 文献和实验
- 技术资料
- 英文名:
DB
- 库存:
1×10^6
- 供应商:
澳音生物
- 肿瘤类型:
--
- 细胞类型:
B淋巴母细胞
- 品系:
--
- 组织来源:
腹水
- 相关疾病:
大细胞淋巴瘤
- 物种来源:
--
- 免疫类型:
--
- 细胞形态:
淋巴母细胞
- 是否是肿瘤细胞:
是
- 器官来源:
--
- 运输方式:
复苏发货或干冰冷冻发货
- 年限:
∞
- 生长状态:
悬浮
- 规格:
T25
[通过STR鉴定]
以上产品图片均为本公司细胞出入库时拍摄
培养条件:
培养基:1640 ,90%;胎牛血清10%;
气相:空气95%,二氧化碳5%
温度:37°C
STR鉴定:
ATCC参考图:
收到货后处理方式: 1.细胞冻存管: 收到货物后,请检查箱子里面是否还有干冰。 ● 若干冰已剩余不多,不能掩埋冻存管,请及时拍照,并第一时间联系销售。 ● 若干冰充裕,可以安排复苏细胞,复苏方法参考【说明书】;不安排复苏,请将细胞冻存管转移到液氮进行保存。短期(一周内)的存放可以放在-80冰箱,建议最好保存在液氮中。 2.培养瓶的活细胞: 收到请检查培养瓶是否完好,是否有漏液,培养基是否浑浊 ●若出现以上问题请于当天和我们销售取得联系,我们会第一时间为您处理。 ● 若以上问题都没有出现:拆掉培养瓶的外包装,在显微镜下对细胞进行多个视野,不同倍镜拍照。然后用酒精对瓶身进行彻底消毒,放在37度二氧化碳培养箱中进行复温。1-2小时后,拿出在显微镜下观察,并进行多个视野不同倍镜拍照。若细胞达到了可以传代的密度,请按照【说明书】的传代方法进行操作。若细胞密度不能进行传代,请回收培养瓶中的培养基,留适量培养基在瓶中,并将培养瓶放在培养箱继续培养即可(个别细胞除外,详见说明书)
仅供研究之用
联系我们:
风险提示:丁香通仅作为第三方平台,为商家信息发布提供平台空间。用户咨询产品时请注意保护个人信息及财产安全,合理判断,谨慎选购商品,商家和用户对交易行为负责。对于医疗器械类产品,请先查证核实企业经营资质和医疗器械产品注册证情况。
文献和实验The Wound Watch: An Objective Staging System for Wounds in the Diabetic (db/db) Mouse Model
As in cancer biology, in wound healing there is a need for objective staging systems to decide for the best treatment and predictors of outcome. We developed in the diabetic (db/db) wound healing model, a staging system, the “wound watch
The leptin receptor deficient db/db mouse has served as a rodent model for obesity and type 2 diabetes for more than 40 years. Diabetic features in db/db mice follow an age-dependent progression, with early insulin resistance followed
proteins into ortholog groups based on their sequence similarity. OrthoMCL?DB is a public database that allows users to browse and view ortholog groups that were pre?computed using the OrthoMCL algorithm. Version 4 of this database contained 116,536
技术资料暂无技术资料 索取技术资料

![K-562[K562; K 562; GM05372; GM05372E]慢性髓系白血病细胞](https://img1.dxycdn.com/2020/0328/548/3404619381585204914-14.jpg!wh200)


